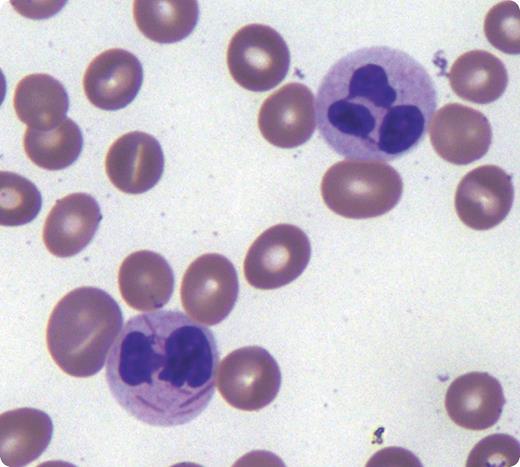
A 37-year-old woman initially presented with pancytopenia and found to have leukopenia (2.1 × 103/μL) with 13% atypical promyelocytes, anemia (hemoglobin of 6.8 g/dL), and thrombocytopenia (41 000 per μL). The atypical promyelocytes were medium to large in size with frequent bilobed nuclei, fine chromatin, and abundant cytoplasmic granules with occasional Auer rods. She was diagnosed with acute promyelocytic leukemia (APL) following a bone marrow (BM) biopsy. Molecular studies confirmed the unique (15;17) chromosomal translocation. She was admitted and started on all-trans retinoic acid (ATRA) therapy. On day 16 of her hospitalization and treatment, her peripheral blood smear showed hypogranular neutrophils with decreased secondary granules and cytoplasmic inclusions consistent with Auer rods. / ATRA is used as a therapeutic agent in patients with APL to induce the differentiation of leukemic cells. Neutrophils in the BM and blood of patients during ATRA treatment occasionally contain Auer rods, consistent with their derivation from leukemic cells. Although ATRA is effective in inducing differentiation of APL cells, it is incapable of inducing complete neutrophil morphologic maturation. In addition to APL, Auer rods in neutrophils are also described in acute myeloid leukemia (AML) t(8;21), AML with maturation, and mixed lineage leukemia.

A 37-year-old woman initially presented with pancytopenia and found to have leukopenia (2.1 × 103/μL) with 13% atypical promyelocytes, anemia (hemoglobin of 6.8 g/dL), and thrombocytopenia (41 000 per μL). The atypical promyelocytes were medium to large in size with frequent bilobed nuclei, fine chromatin, and abundant cytoplasmic granules with occasional Auer rods. She was diagnosed with acute promyelocytic leukemia (APL) following a bone marrow (BM) biopsy. Molecular studies confirmed the unique (15;17) chromosomal translocation. She was admitted and started on all-trans retinoic acid (ATRA) therapy. On day 16 of her hospitalization and treatment, her peripheral blood smear showed hypogranular neutrophils with decreased secondary granules and cytoplasmic inclusions consistent with Auer rods.
ATRA is used as a therapeutic agent in patients with APL to induce the differentiation of leukemic cells. Neutrophils in the BM and blood of patients during ATRA treatment occasionally contain Auer rods, consistent with their derivation from leukemic cells. Although ATRA is effective in inducing differentiation of APL cells, it is incapable of inducing complete neutrophil morphologic maturation. In addition to APL, Auer rods in neutrophils are also described in acute myeloid leukemia (AML) t(8;21), AML with maturation, and mixed lineage leukemia.
A 37-year-old woman initially presented with pancytopenia and found to have leukopenia (2.1 × 103/μL) with 13% atypical promyelocytes, anemia (hemoglobin of 6.8 g/dL), and thrombocytopenia (41 000 per μL). The atypical promyelocytes were medium to large in size with frequent bilobed nuclei, fine chromatin, and abundant cytoplasmic granules with occasional Auer rods. She was diagnosed with acute promyelocytic leukemia (APL) following a bone marrow (BM) biopsy. Molecular studies confirmed the unique (15;17) chromosomal translocation. She was admitted and started on all-trans retinoic acid (ATRA) therapy. On day 16 of her hospitalization and treatment, her peripheral blood smear showed hypogranular neutrophils with decreased secondary granules and cytoplasmic inclusions consistent with Auer rods.
ATRA is used as a therapeutic agent in patients with APL to induce the differentiation of leukemic cells. Neutrophils in the BM and blood of patients during ATRA treatment occasionally contain Auer rods, consistent with their derivation from leukemic cells. Although ATRA is effective in inducing differentiation of APL cells, it is incapable of inducing complete neutrophil morphologic maturation. In addition to APL, Auer rods in neutrophils are also described in acute myeloid leukemia (AML) t(8;21), AML with maturation, and mixed lineage leukemia.
For additional images, visit the ASH IMAGE BANK, a reference and teaching tool that is continually updated with new atlas and case study images. For more information visit http://imagebank.hematology.org.